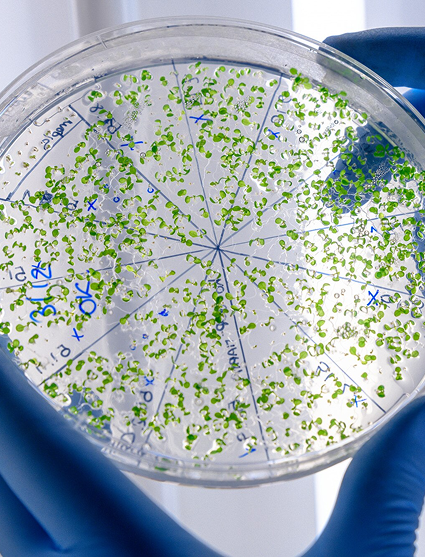
bacterias en un recipiente redondo

Bienvenido a Bio World Organic
La naturaleza y la biotecnología se unen para crear soluciones poderosas, sostenibles y efectivas.
Nos enorgullece ser tus aliados en la mejora de cultivos, el compostaje eficiente y el tratamiento de balsas de agua, siempre enfocados en un objetivo claro: maximizar tus resultados mientras cuidamos del medio ambiente.
Agricultura sostenible
Nuestro enfoque en la agricultura va más allá de los productos tradicionales.
Con nuestros microorganismos vivos, mejoramos la salud del suelo, fortalecemos la resistencia natural de las plantas y reducimos la necesidad de productos químicos.
Cada cosecha es una oportunidad para demostrar que lo natural puede ser aún más efectivo, y nuestros clientes ya están viendo la diferencia en sus campos.
Compostaje eficiente
La gestión de residuos es clave para cualquier operación agrícola.
Con nuestros productos, aceleramos el proceso de compostaje, transformando desechos en valioso fertilizante en menos tiempo y con mayor calidad.
De esta forma, convertimos lo que antes era un problema en una solución productiva, haciendo tu sistema más autosuficiente y rentable.
Tratamiento de balsas
El agua es la base de cualquier producción agrícola, y su calidad no puede dejarse al azar.
Tratamos balsas de agua con soluciones que reducen gases nocivos como el amoníaco, mejorando la salud de los cultivos y animales.
Garantizando un entorno más limpio y eficiente. No se trata solo de optimizar el uso del agua, sino de cuidar el ecosistema que la rodea.
Un compromiso real con el futuro de tu negocio y el planeta
Bio World Organic no es solo una empresa, es una filosofía de trabajo. Creemos que el éxito llega al respetar el equilibrio natural, y por eso cada solución que ofrecemos está diseñada para lograr resultados tangibles y sostenibles.
Trabajamos codo a codo contigo para que no solo veas la diferencia en tus números, sino también en la calidad de tus tierras y el impacto positivo en el entorno.
Descubre la biotecnología que está revolucionando la agricultura. Bio World Organic – Cosecha, compost y agua, optimizados naturalmente.
¿Por qué elegir Bio World Organic?

Potencian la microbiota del suelo para mejorar la salud de las plantas y maximizar la eficiencia del cultivo.

Fortalecemos las defensas naturales de las plantas, reduciendo la necesidad de productos químicos.

Cada solución está diseñada para ofrecer los mejores resultados, optimizando cada fase del proceso agrícola.
Conocimiento que cultiva resultados
Consulta artículos sobre las últimas tendencias en biotecnología agrícola, fertilización natural y sostenibilidad.

